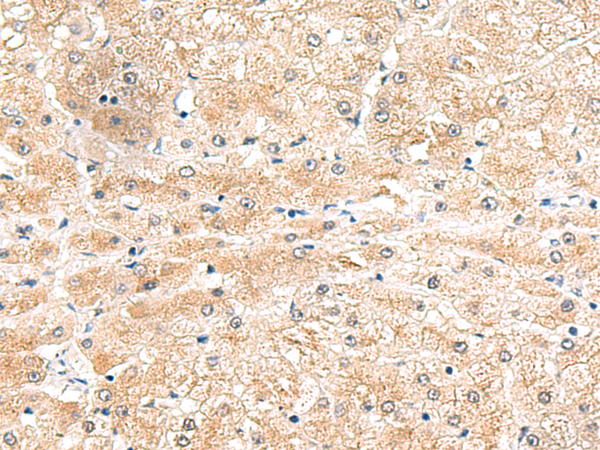
一抗

|
Background: |
The leucine-rich repeat (LRR) family of proteins, including LRG1, have been shown to be involved in protein-protein interaction, signal transduction, and cell adhesion and development. LRG1 is expressed during granulocyte differentiation (O'Donnell et al., 2002 [PubMed 12223515]). |
|
Applications: |
ELISA, IHC |
|
Name of antibody: |
LRG1 |
|
Immunogen: |
Fusion protein of human LRG1 |
|
Full name: |
leucine rich alpha-2-glycoprotein 1 |
|
Synonyms: |
LRG; HMFT1766 |
|
SwissProt: |
P02750 |
|
ELISA Recommended dilution: |
5000-10000 |
|
IHC positive control: |
Human liver cancer |
|
IHC Recommend dilution: |
50-300 |

 購物車
購物車 幫助
幫助
 021-54845833/15800441009
021-54845833/15800441009